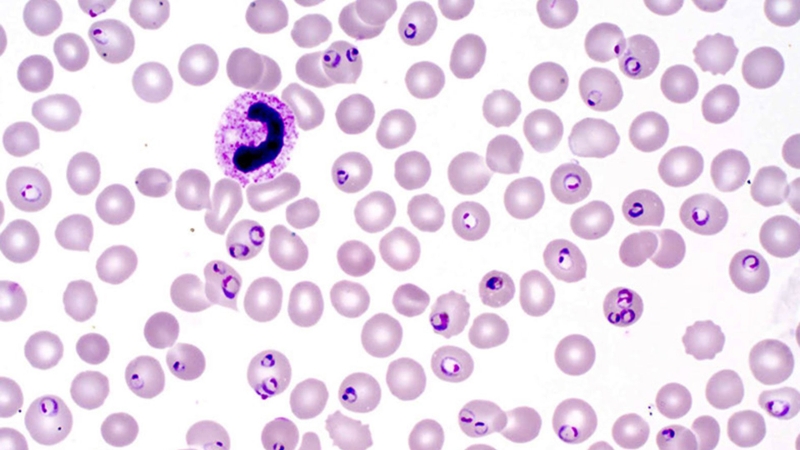
Soi ký sinh trùng sốt rét là phương pháp được sử dụng phổ biến trong chẩn đoán bệnh

Từng làm ở Viện ISDS, nhiều năm cộng tác với CDC Thái Nguyên triển khai dự án phòng chống HIV/AIDS, 2 năm cộng tác với WHO.
Tuệ Nghi
03/12/2025
Mặc định
Lớn hơn
Soi ký sinh trùng sốt rét là phương pháp xét nghiệm vi sinh giúp phát hiện trực tiếp ký sinh trùng gây bệnh sốt rét trong máu người bệnh. Đây là kỹ thuật đơn giản, chi phí thấp nhưng có độ chính xác cao, được coi là “tiêu chuẩn vàng” trong chẩn đoán sốt rét hiện nay.
Sốt rét là bệnh truyền nhiễm nguy hiểm do muỗi Anopheles truyền ký sinh trùng Plasmodium sang người. Trong chẩn đoán bệnh, xét nghiệm soi ký sinh trùng sốt rét đóng vai trò cực kỳ quan trọng, giúp xác định chính xác người bệnh có nhiễm ký sinh trùng hay không đồng thời hướng dẫn điều trị hiệu quả, tránh nhầm lẫn với các bệnh lý khác có biểu hiện sốt tương tự.
Soi ký sinh trùng sốt rét là kỹ thuật dùng kính hiển vi để quan sát trực tiếp ký sinh trùng Plasmodium trong mẫu máu của người nghi ngờ mắc bệnh. Đây là phương pháp cổ điển nhưng đến nay vẫn được Tổ chức Y tế Thế giới (WHO) và Trung tâm Kiểm soát và Phòng ngừa Dịch bệnh Hoa Kỳ (CDC) khuyến nghị sử dụng rộng rãi. Với lịch sử phát triển từ cuối thế kỷ 19, khi nhà khoa học Charles Laveran lần đầu phát hiện ký sinh trùng sốt rét dưới kính hiển vi, kỹ thuật này đã trở thành nền tảng trong chẩn đoán vi sinh học.
Khi ký sinh trùng sốt rét xâm nhập vào cơ thể, chúng ký sinh trong hồng cầu và trải qua các giai đoạn phát triển như thể vòng, thể nuôi, thể phân liệt và giao bào. Kỹ thuật viên sẽ lấy máu, tạo lam máu mỏng và lam máu dày sau đó nhuộm bằng dung dịch Giemsa. Dưới kính hiển vi quang học, bạn có thể nhìn thấy hình dạng đặc trưng của ký sinh trùng như vòng nhẫn, thể phân liệt hoặc giao bào từ đó xác định loài Plasmodium (P. falciparum, P. vivax, P. malariae, P. ovale hoặc P. knowlesi).
Quá trình soi ký sinh trùng sốt rét dựa trên sự khác biệt về hình thái giữa các loài. Việc nhận diện chính xác giúp dự đoán diễn tiến bệnh.
Quy trình soi ký sinh trùng sốt rét gồm nhiều bước, đòi hỏi sự chính xác và tuân thủ kỹ thuật nghiêm ngặt để đảm bảo độ tin cậy của kết quả. Toàn bộ quá trình thường được thực hiện tại phòng xét nghiệm vi sinh, với sự giám sát chất lượng theo hướng dẫn của WHO.
Việc lấy mẫu cần tuân thủ các nguyên tắc sau để đảm bảo chất lượng:

Có hai loại lam máu cần thực hiện song song trong soi ký sinh trùng sốt rét, với kỹ thuật cụ thể như sau:
Cả hai lam phải được làm khô tự nhiên ở nhiệt độ phòng, tránh nắng trực tiếp hoặc quạt mạnh để ngăn biến dạng hồng cầu.
Quá trình nhuộm và quan sát được thực hiện theo các bước sau:

Kết quả được đọc và báo cáo dựa trên các tiêu chí sau:
Quy trình soi ký sinh trùng sốt rét đòi hỏi ít nhất hai kỹ thuật viên độc lập đọc lam ở cơ sở lớn để tăng độ chính xác.

Để soi ký sinh trùng sốt rét đạt hiệu quả cao, người bệnh cần tuân thủ các hướng dẫn sau để hỗ trợ quá trình xét nghiệm:

Soi ký sinh trùng sốt rét là xét nghiệm cơ bản nhưng đóng vai trò quan trọng trong phát hiện và kiểm soát bệnh sốt rét. Mong rằng, với những chia sẻ hôm nay, bạn đọc sẽ có cái nhìn rõ hơn về phương pháp soi ký sinh trùng sốt rét. Cảm ơn bạn đã dành thời gian đón đọc bản tin sức khỏe hôm nay của Nhà thuốc Long Châu.
Dược sĩ Đại học Nguyễn Tuấn Trịnh
Từng làm ở Viện ISDS, nhiều năm cộng tác với CDC Thái Nguyên triển khai dự án phòng chống HIV/AIDS, 2 năm cộng tác với WHO.